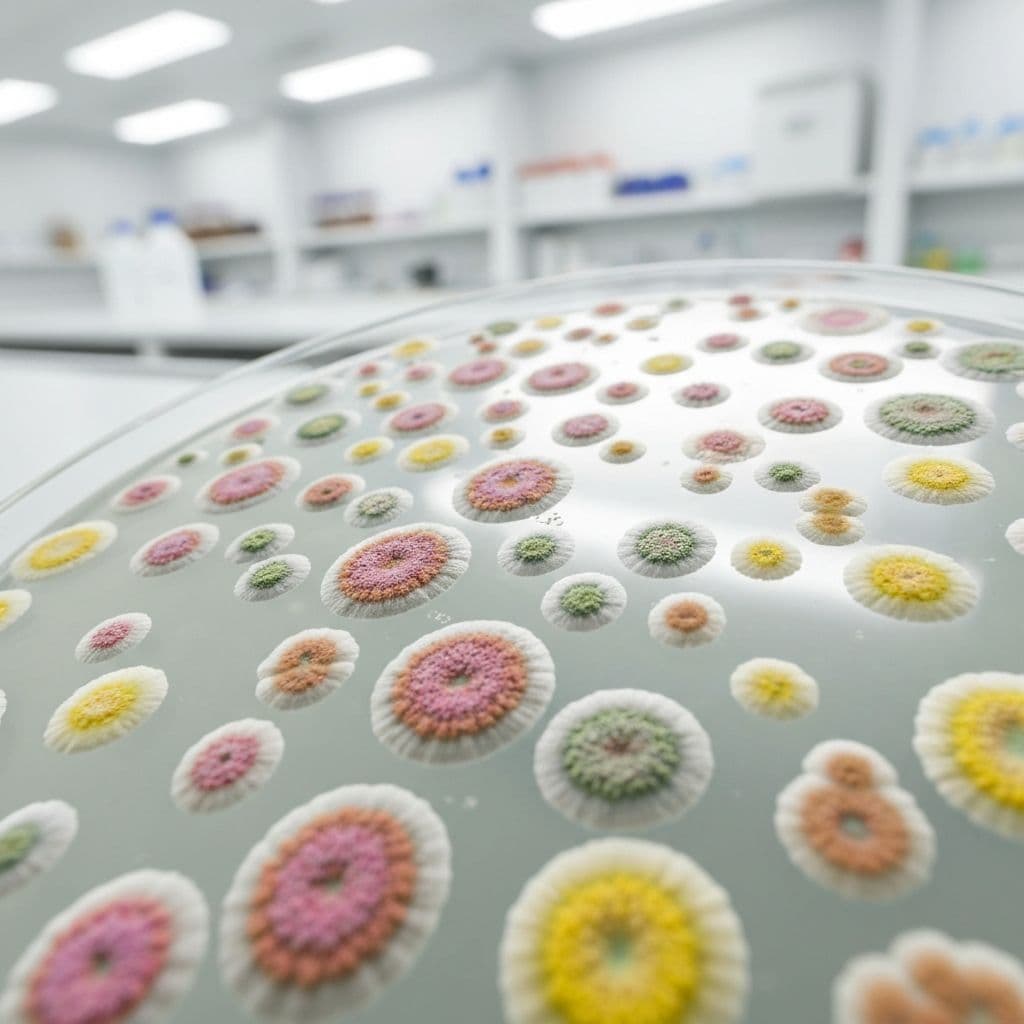
Biostimulant Strain Identification

Transforming the impossible into innovation
Scientific rigor, field-ready innovation
Biomat bridges cutting-edge biotechnology with on-ground farming realities, helping growers unlock predictable, sustainable performance from every hectare.
We are a biotechnology company dedicated to transforming agriculture through science-driven, sustainable solutions. Our team combines expertise in microbiology, genomics, and computational biology to design products that enhance crop productivity, improve soil health, and reduce dependence on chemical inputs.
From biofertilisers and biostimulant strain identification to in-silico screening, genome analysis, and custom microbial blends, every solution is built to perform reliably in diverse field conditions—not just in controlled trials.
10+
Years of combined R&D experience
4+
Core biotech capabilities in-house
100%
Focus on sustainable agriculture

Inside the lab
From microbe to market-ready solution
We validate every candidate through a rigorous pipeline—from in-vitro characterisation and genomic analysis to greenhouse and multi-location field trials—so that only robust, repeatable solutions reach our partners.
Quality by design
Standardised, traceable R&D workflows.
Farmer-centric
Formulations optimised for real-world handling.
Our mission
Our mission is to bridge the gap between cutting-edge research and real-world farming challenges. By collaborating closely with farmers, researchers, and industry partners, we ensure our innovations address practical needs while contributing to global food security and environmental resilience.
Every product we create is backed by rigorous science, field validation, and a commitment to protecting the ecosystems that sustain agriculture. Together with our partners, we are cultivating a future where productivity and sustainability reinforce each other—not compete.

Our Innovations
Where science meets the impossible
Translating frontier microbiome, genomic and in-silico research into practical solutions that create resilient, high-performing farms.
Beneficial Microorganisms
Harnessing the power of beneficial microorganisms to improve soil health and boost crop productivity naturally.
Advanced Genomic Tools
Using cutting-edge genomic tools to develop resilient crop varieties that can withstand environmental stresses.
In-Silico Innovations
Leveraging computational biology and AI to accelerate discovery and reduce reliance on chemical inputs.

Our Mission
Committed to developing sustainable, science-driven solutions for modern agriculture
Our work focuses on harnessing the power of beneficial microorganisms, advanced genomic tools, and in-silico innovations to improve crop productivity, enhance soil health, and reduce reliance on chemical inputs.
By partnering directly with farmers, we ensure every breakthrough is rigorously tested, economically viable, and adapted to real-world conditions across diverse geographies and crops.
Read More About Us→Our Products
Science-driven solutions designed to enhance agricultural productivity while protecting our planet.

Biofertilizers
We develop high-performance biofertilisers that work in harmony with natural soil ecosystems to enhance nutrient cycling and improve plant growth. By harnessing beneficial microbes, our formulations help crops absorb essential nutrients more efficiently, reduce the need for synthetic fertilisers, and promote long-term soil health.

Biostimulant Strain Identification
Our advanced biostimulant strain identification process focuses on discovering microbial strains with proven plant-growth-promoting properties. We carefully screen and characterise beneficial microbes that enhance root development, improve nutrient uptake, and increase resilience against environmental stress.

In-Silico Screening
We utilise cutting-edge in-silico screening methods to accelerate product development and improve accuracy. By using predictive computational models, we can identify the most promising microbial candidates and chemicals before entering extensive field trials.

Genome Analysis
Our genome analysis capabilities allow us to delve deep into the genetic makeup of beneficial microbes, uncovering traits that can enhance crop performance. By mapping microbial DNA, we identify genes responsible for nutrient efficiency, stress tolerance, and disease resistance.
Custom Blend Development
We specialise in creating custom semiochemical blends that combine complementary lures and repellents for maximum impact. Each blend is carefully designed to suit specific pest, ensuring optimum compatibility and performance across diverse farming systems.
Our Impact
From soil to society
Our innovations create real-world change that can be measured in healthier soils, stronger crops, and more resilient farming communities.

Yield Improvement
increase in target crops

Climate Resilience
crops withstand extreme weather

Plant DNA Solutions
genome-driven crop optimization
Empowering Farmers & Communities
Stronger Farmers. Thriving Communities. A Sustainable Future.
Our solutions are designed to equip farmers with the tools, knowledge, and confidence to grow more with less—less chemical input, less environmental impact, and less uncertainty.
Improved Yields
Grow more with less chemical input and environmental impact
Reduced Costs
Lower input costs and secure stable incomes for your farm
Community Support
Access to premium markets and investment opportunities


